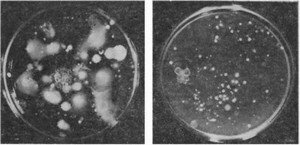

ВИРУСЫ И ФАГИ
Это особая группа чрезвычайно мелких паразитов, способных развиваться только внутри клеток других организмов — растений, животных, водорослей, грибов, бактерий и актиномицетов, вызывая болезнь макроорганизма или полную гибель микробных клеток.
Иначе их называют ультрамикроскопическими формами, так как их можно видеть только в электронный микроскоп. К вирусам относят паразитов живот-
Рис. 37. Фаги
Слева два типа негативных колоний ризобиофага, справа — два типа фаговых частиц
ных и растений, к фагам — паразитов микроорганизмов (альго-, мико-, бактерио- и актинофаги).
Вирусы и фаги не имеют клеточного строения, они существуют в виде особых инфекционных частиц — вирионов. Вирусы были открыты в конце прошлого века Д. И. Ивановским при исследовании болезни табака — табачной мозаики. Он назвал возбудителей этой болезни фильтрующимся вирусом, так как инфекционные частицы проходили через бактериальные фильтры. Вирус табачной мозаики (ВТМ) в 1935 г. был получен в кристаллической форме У. Стенли. Его вирионы имеют форму многогранника. Вирионы других вирусов различаются формой и размерами. Они бывают палочковидные, нитевидные, сферические, цилиндрические. Каждый вирион состоит из нуклеиновой кислоты (ДНК или РНК) и белковой оболочки — капсида, который сложен из отдельных единиц — капсомеров. Фаги были описаны позже, чем вирусы (1915, 1917), Ф. Туортом и Ф. д’Эррелем независимо друг от друга. Вирусы прокариот, или бактериофаги, состоят из головки и хвостового отростка, которым они прикрепляются к клетке-хозяину. Через этот отросток в клетку вводится («впрыскивается») фаговая ДНК по типу шприца. Количество вновь синтезированных в одной клетке вирусных частиц («выход фага») может достигать нескольких сотен. На газоне чувствительной к фагу бактерии образуются зоны лизиса — «негативные колонии» (рис. 37). По их числу можно узнать содержание фаговых частиц в почве или другом субстрате, т. е. определить титр фага. В почве вирусы не размножаются, но сохраняются в ней длительные сроки. При проникновении в бактериальные клетки они не обязательно вызывают их немедленную гибель, но передаются при делении. В этом случае фаг называют умеренным, а бактерии — его носители — лизогенными. Скрытый фаг при ослаблении клеток хозяина может вызвать их лизис. Фаги специфичны, они поражают только определенные виды клеток или группы близкородственных организмов.
Фаги могут наносить существенный ущерб в микробиологических производствах, в том числе при изготовлении бактериальных удобрений, например нитрагина.
Еще по теме ВИРУСЫ И ФАГИ:
- ВИРУСЫ И ФАГИ
- ЭКОЛОГИЯ И НОЗОГЕОГРАФИЯ ВИРУСОВ
- О ТЕРАТОГЕННОМ ДЕЙСТВИИ ВИРУСОВ
- РАСТЕНИЯ-ИНДИКАТОРЫ В БОРЬБЕ С ВИРУСАМИ
- ЧРЕЗВЫЧАЙНЫЕ СИТУАЦИИ С УЧАСТИЕМ ВИРУСОВ
- ВОЗНИКНОВЕНИЕ И РАЗВИТИЕ УЧЕНИЯ О ВИРУСАХ БАКТЕРИЙ
- АДЕНОВИРУСНАЯ ИНФЕКЦИЯ ПТИЦ, ВЫЗЫВАЕМАЯ ВИРУСАМИ CELO И GAL
- УСОВЕРШЕНСТВОВАНИЕ МЕТОДОВ КУЛЬТИВИРОВАНИЯ ВИРУСОВ
- ПЕРЕНОСЧИКИ ВИРУСОВ И МИКОПЛАЗМ ТЛИ (АркісНсіае, Моторі его)
- ЧАСТЬ I. ЗАБОЛЕВАНИЯ, ВЫЗЫВАЕМЫЕ РНК-СОДЕРЖАЩИМИ ВИРУСАМИ
- ЧАСТЬ II. ИНФЕКЦИИ, ВЫЗЫВАЕМЫЕ ДНК-СОДЕРЖАЩИМИ ВИРУСАМИ
- МЕТОДЫ ДИАГНОСТИКИ И МЕРЫ БОРЬБЫ С ВИРУСНЫМИ И МИКОПЛАЗМЕННЫМИ БОЛЕЗНЯМИ, ПЕРЕНОСЧИКИ ВИРУСОВ И МИКОПЛАЗМ
- ХАРАКТЕРИСТИКА ВОЗБУДИТЕЛЯ
- ХАРАКТЕРИСТИКА ВОЗБУДИТЕЛЯ
- ДубровинВ, и др. Ветеринарная газета., 1996, 14 ЭПИДЕМИЧЕСКИЙ ПАРОТИТ (СВИНКА) Mumps infectious
- ХАРАКТЕРИСТИКА ВОЗБУДИТЕЛЯ
- РАЗВИТИЕ ФИТОВИРУСОЛОГИИ
- ХАРАКТЕРИСТИКА ВОЗБУДИТЕЛЯ